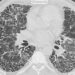
Akciğer Sertleşmesi İçin Yeni Bir İlaç

Yaşama anlam katan nedir? Hayatın akışında gelişen olaylar ve karşımıza çıkan kişiler. Kimi zaman pozitif, kimi zaman da negatif etkiler yaratan bu unsurlar olmazsa yaşam monoton ve heyecansız bir süreçten öteye geçemez asla.
Nitekim yaşamın yansımaları diyebileceğimiz kurgular için de durum aynı. Nasıl gelişeceği bilinmeyen olaylarla ve çatışmacılıkla yaratılan içeriklerin yanı sıra renkli karakterlerin varlığı da kurguları tekdüzelikten kurtarıp ilgi çekici hale getirir.
Hal böyleyken ekrandaki dizilere baktığımızda gerek performans gerekse özellik bakımından en bol renkli karakteri bünyesinde barındıran yapım olarak ‘Kefaret’ dikkatimizi çekmekte. Zira diğer işlerde de öne çıkan ilginç tiplemler olsa bile, burada kadınından erkeğine ve dahi çocuğuna topyekûn renklilik hâkim! Dahası aralarında abartıya kaçan ya da uyumsuz durarak sırıtan yok. Dolayısıyla keyifle izlediğim ve sürekli final söylentilerine maruz kalarak yıpratıldığını düşündüğüm dizinin renkli karakterlerini vurgulamamanın emeğe haksızlık olacağı kanaatindeyim.
KEFARET’İ İLGİNÇ KILANLAR
Mahinur Ergun-Mesude Erarslan ikilisinin senarist-yönetmen kanadında başarıyla yer aldıkları ‘Kefaret’i ilginç kılan unsur, başlarda Zülfü Livaneli’nin ‘Konstantiniyye Oteli’ romanından uyarlanması olmuştu. Lakin süreç içinde diziyi ilginçleştirip izlenir kılan asıl detay, her biri kendine has duruş sergileyen karakterleri haline geldi!
İhanetle gelen intikamcılığın çocuk kaçırmaya varma noktasından hareketle karşımıza çıkıp bir annenin bıkıp usanmadan kızını bulma umuduna odaklanan yapım, o süreçte sırlara dayalı konusuyla cezbetmişti bizi. Ancak Sude ve Cansu hakkındaki gerçekler açığa çıktıktan sonra başlangıçtan itibaren var olmakla birlikte ikinci planda kalan karakterlerin renkli özellikleri daha ağır basar oldu. Karakterler bazında kısaca detaylandırırsak…
Nurgül Yeşilçay’la adeta özdeşleşen Zeynep, bana göre oldukça enteresan bir tip. Şöyle ki; klasik aldatılmış kadın modeline uymuyor ve mağdur anne dramatikliğine soyunmuyor. Onun yerine kendisini yakın arkadaşıyla aldatan kocasıyla neredeyse kanka oluyor. Yani Zeynep Ahmet’e karşı dizilerde çokça rastladığımızdan oldukça farklı davranıyor. Öfkelense bile önceliğini çocuklarına verdiği için onların ruh halini bozmaktan kaçınarak bunu yansıtmıyor. Keza yeniden kurduğu hayat düzeniyle ilgili dertlerini paylaşıp yeri geldiğinde kolladığı Ahmet’e de aşk tavsiyelerinde bile bulunuyor.
Kısacası Ahmet’in kendisini aldattığı Meltem’le birlikte çalışmaktan gocunmayan… Hatta onu kurtarmak için Arzu’nun ayağına koşturup canını tehlikeye atmaktan çekinmeyen… Kızını alıkoyan Mehmet’e bile iş veren… Ve Sinan’ı çok sevdiğini söylemekle birlikte ondan kolayca vazgeçmekten çekinmeyerek tacizci konumuna düşüren Zeynep, rutini aşan bir kadın!
Özge Özacar’ın canlandırdığı Meltem de ‘Kefaret’in özgün renklilerinden… Pervasızlık boyututundaki tavırlarıyla her şeyi kendine hak sayması bir yana, kocasını elinden aldığı Zeynep’le etkileşimi apayrı bir boyutta. Cansu’nun Arzu tarafından alıkonulduğunu bile bile sırf Ahmet’i elinden kaçırmamak için yıllarca susan Meltem bu boyutta melek görünümlü şeytan halini alıyor. Dizi boyunca her türlü marazın, oyun bazlığın kökeni o oldu zaten. Nitekim Alp’i elde etmek için uslanmış gibi görünüp Zeynep’le çalışsa bile kreş olayından kazançlı çıkmak uğruna yine dümen peşinde. Velhasıl Meltem utanmak bilmeyen, ölçüsüzce hareket etmekten çekinmeyen ve su gibi yalan söyleyip menfaatini her daim ön planda tutan renklilikte biri. Bakalım planlarında başarıya ulaşacak mı? Göreceğiz.
Ve Selcen Ezgi Dinçer’in performansıyla ‘Kefaret’i süper kahraman-hafiye kıvamına sokan Fulya… Mesleğinde ilerlemek için Emre Komiser ile ilişkisini noktalamaktan çekinmeyen… Sinan kayıplara karışınca yerini tespit etmek için illegal biçimde gizli dosyalara erişip başına iş açan… Zeynep kaçırıldığı için düğünü ertelenince içindeki şeytanı açığa çıkartıp şirretleşen… Sonra bir anda motorlu süper kahramana dönüşüp mafyayı tarumar ederek Kadir’in paralarını ve Zeynep’i kurtaran… Ev kadınlığından bıkınca boş vakitlerinde adrenalin olsun diye sokak serserilerini pataklayıp kazık yemiş kadınların dertlerini halleden hafiyeye evrilen Fulya ekürisi Deniz ile birlikte mükemmel bir renk katıyorlar diziye. Karakter açısından Sinan’la iyi bir çift olabilecek Fulya kocasının evi terk etmesiyle uslanır mı derseniz… Hiç sanmam. Aynen devam.
SONUÇTA; Geçmişte yıllar boyu Zeynep için koşturup varını yoğunu onun kızını bulması için harcayarak sonunda polislikten atıldığı halde evlendikten sonra mesleğini ve bağımsızlığını aşktan üstün tutma triplerine girerek evi terk eden Sinan…
Sırf ailesini kızdırmak için Meltem ile birlikte yaşarken ‘Aşk yok’ şartını öne süren… Buna karşılık tüm kötülüklerini, paragözlüğünü ve yalancılığını bildiği Meltem’i yola getirme çabasına girerek ona kur yapmaktan geri durmayan Alp…
Boylarından büyük konuşmalarla ‘Şimdiki çocuklar bir başka’ dedirten Sude ve Cansu…
Kaçırılmış bir çocuğu sahiplenmesi yetmiyormuş gibi onun babasına da aşık olarak aşırı saflıkla tüm parasını kaptırıp sefalete sürüklenen ve bir de üstüne üstlük bu adamdan hamile kalan Arzu… Cümlesi ‘Kefaret’in karakterlerle renklenip ilginçleştiğinin yansımaları.
‘Kefaret’i ilginç kılan renklilikleri saptaması bizden takdiri izleyenden… Bunca renkliliği görmezden gelenlere karşı son söz Necip Fazıl Kısakürek’ten… ‘Renkleri ince ince ne anlatırsın köre, konuşun insanlarla akıllarına göre’.
Anibal GÜLEROĞLU
guleranibal@yahoo.com
www.twitter.com/guleranibal